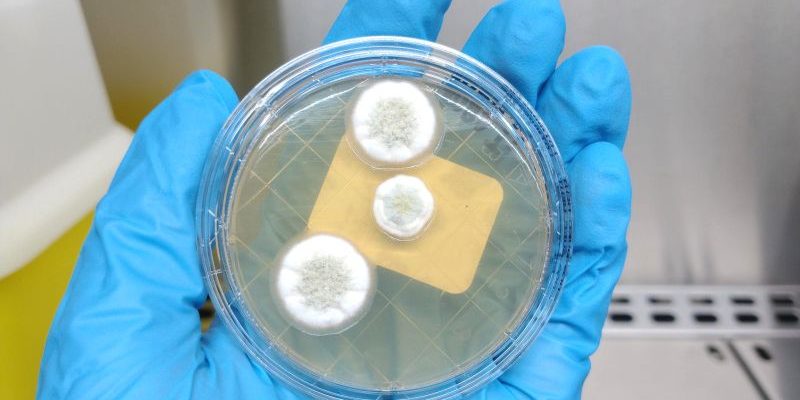

Los análisis microbiológicos de superficies para detectar hongos son fundamentales para garantizar la seguridad en diversos entornos, ya sea para proteger la salud humana y animal, como para garantizar la calidad de productos.
En la industria alimentaria, la contaminación por hongos puede afectar la calidad y seguridad de los productos. Los hongos pueden producir toxinas que, cuando están presentes en alimentos, pueden causar enfermedades. Estos análisis ayudan a prevenir la contaminación y garantiza la calidad de los productos alimentarios.
En estudios ambientales, el análisis de hongos en superficies puede proporcionar información sobre la calidad del aire y la presencia de contaminantes ambientales. Esto es especialmente importante en entornos donde la calidad del aire puede afectar la salud de las personas o animales.
En los laboratorios, se deben mantener condiciones de trabajo estériles. La presencia de hongos en superficies de laboratorio puede afectar los resultados de los experimentos y análisis, por lo que se realiza un control regular para mantener la calidad y validez de los resultados.